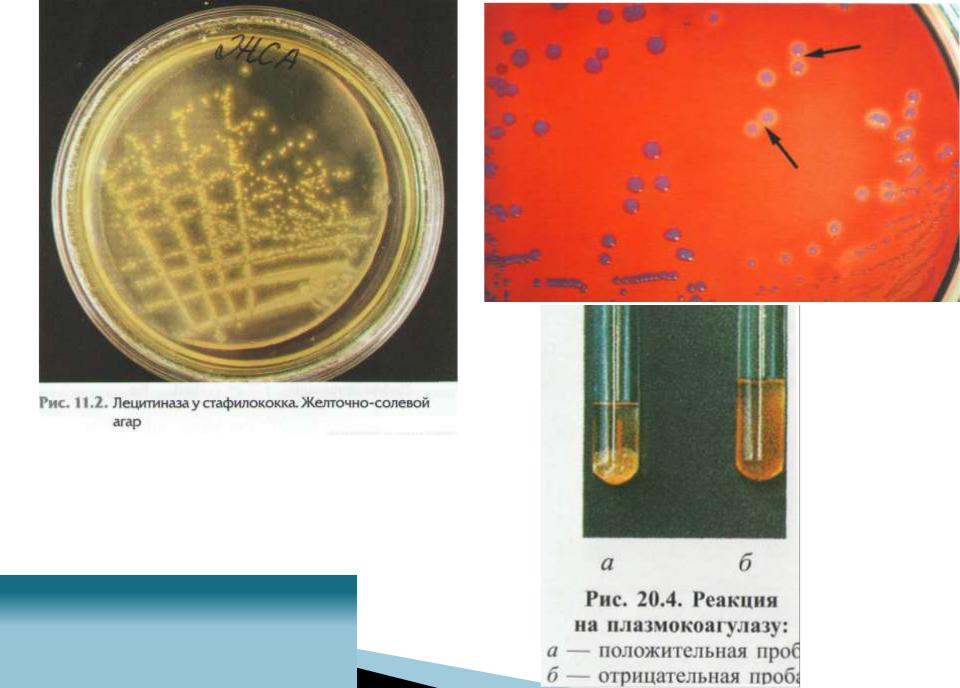

Материал: lektsia_FIZIOLOGIYa_MIKROORGANIZMOV_fiziologia-2020

По биохимическому действию:
1.оксидоредуктазы
2.трансферазы
3.гидролазы
4.изомеразы
5.лигазы
6.лиазы

По локализации относительно микробной клетки:
Экзоферменты |
Эндоферменты |
|
выделяются в окружающую среду:
участвуют в подготовке питательных веществ и их поступлении в клетку («внешнее питание»); повреждающее действие на организм хозяина (ферменты патогенности)
находятся в ЦПМ, цитоплазме, периплазматическом пространстве;
участвуют в процессах переноса веществ в бактериальную клетку.

По постоянству синтеза:
1.Конститутивные (постоянно синтезируются в определенных концентрациях);
2.индуцибельные (находятся в клетке в следовых концентрациях, но при наличии соответствующего субстрата в окружающей среде количество их резко возрастает).

Ферменты патогенности возбудителей инфекционных заболеваний:
1.плазмокоагулаза,
2.нейроминидаза,
3.гиалуронидаза,
4.лецитоветиллаза (лецитиназа),
5.протеиназа,
6.протеаза,
7.ДНК-аза и др.